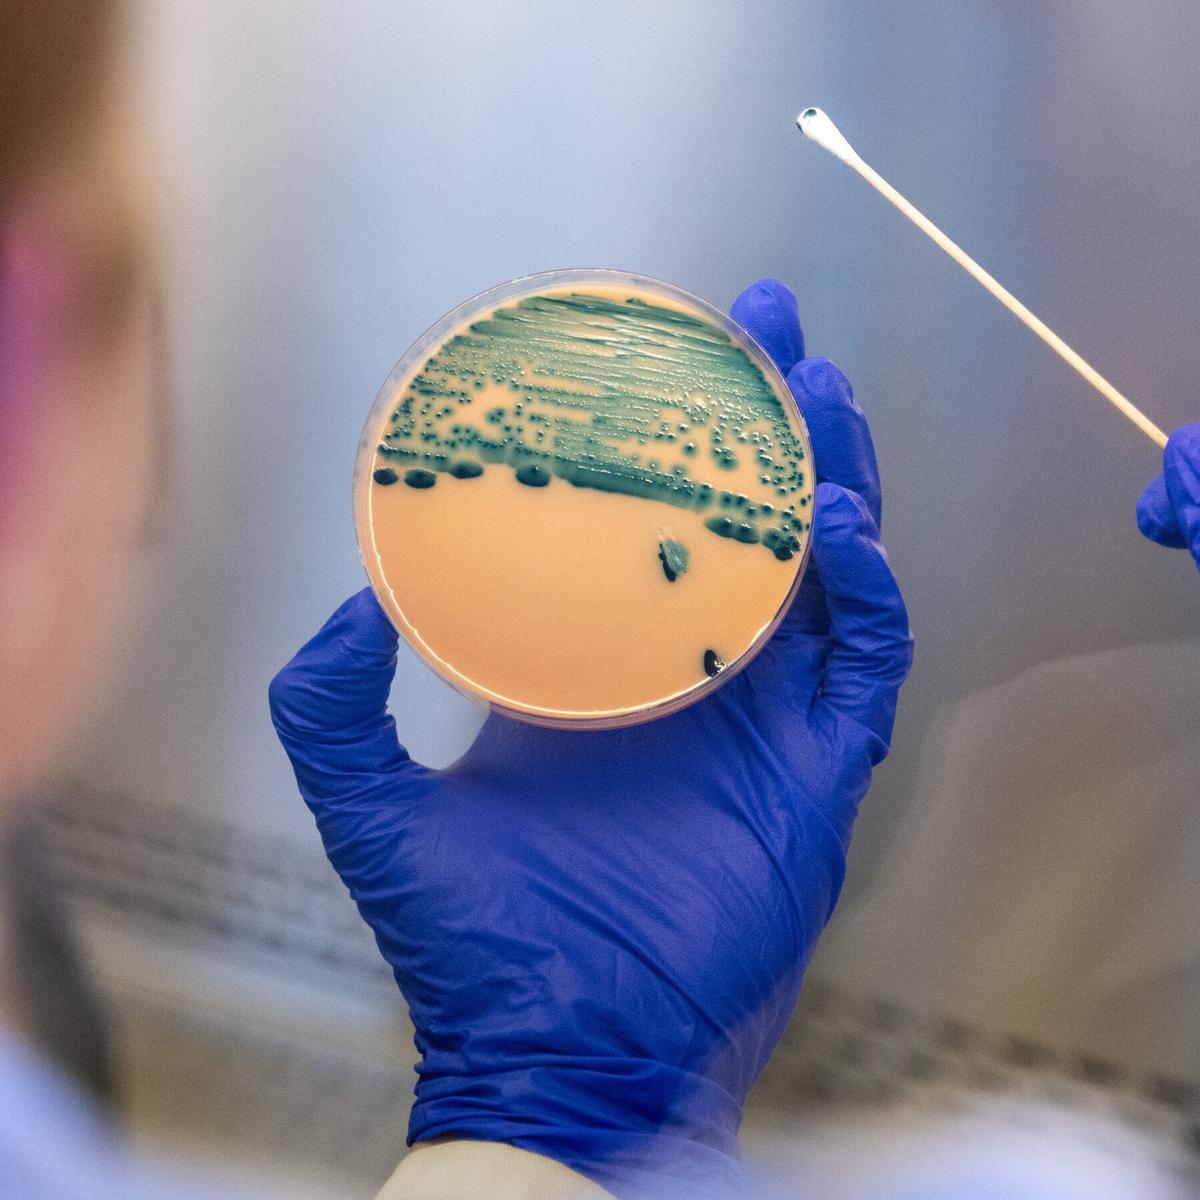
A Common Stomach Bug Has Become Harder to Treat

The Most Prestigious Biglaw Firms In Boston (2027)
Vault’s 2027 regional rankings, compiled from associate‑rated prestige scores, reveal the most coveted biglaw firms in Boston. Ropes & Gray tops the list, followed by Goodwin and WilmerHale, with Latham & Watkins and Kirkland & Ellis also in the upper tier. The ranking reflects a 1‑to‑10 scale based on peer perception, offering a snapshot of the city’s legal hierarchy. The full top‑10 includes Choate Hall & Stewart, Skadden, Mintz, Cooley and Morgan Lewis & Bockius.
Tarkett Expands QuickShip Carpet Program to 85 Products
Tarkett has broadened its QuickShip program to include 85 soft‑surface flooring products that can be delivered within five business days. The expanded lineup adds new colors from the Aftermath III SD and Primary Color collections, alongside existing Powerbond hybrid carpet, ethos carpet tile...

Elevate Podcast: Dr. Shoshana Ungerleider, Founder, End Well Project
The latest Elevate podcast episode features Dr. Shoshana Ungerleider, founder of the End Well Project, discussing how movies, television and broader pop culture shape public perceptions of end‑of‑life care. The conversation explores the ways media influence patient and family expectations,...

FFXIV Is Finally Getting A Switch 2 Port In August, With A Free Early Access--Though There Are Some Caveats
Square Enix announced that the long‑awaited Final Fantasy 14 port for Nintendo Switch 2 will arrive in August, preceded by a free one‑month early‑access soft launch. Unlike other platforms, the Switch version requires a separate game purchase and its own subscription fee....
Ford Rejects Claim of US-Focused Talks With Geely
Ford Motor Co. denied reports that it is negotiating with Geely Automobile Holdings to bring Chinese car technology to the U.S. market, clarifying that talks are confined to a potential use of Ford’s underutilized plant in Spain. Earlier reports suggested...
Healthcare AI Policy Must Keep Humans at the Center
Florida Senator Gayle Harrell, recipient of the HIMSS26 Policy Influencer Changemaker Award, called for AI regulations that keep clinicians in the decision loop. She warned that unchecked AI could erode clinician authority and patient safety. The remarks came amid rapid...

FDA Fast-Tracks the Development of Psychedelic Medications Following President’s Executive Order
The FDA announced an accelerated regulatory pathway for psychedelic‑based therapies after the April 18 executive order targeting serious mental illness. It will prioritize serotonin‑2A agonists for treatment‑resistant depression, PTSD and substance‑use disorders, and issue national‑priority vouchers for psilocybin and methylone studies...
HIMSS Membership Is a 'Game-Changer' For Legislators
HIMSS membership is being touted as a "game‑changer" for lawmakers, according to Florida Senator Gayle Harrell, a HIMSS26 Policy Influencer Changemaker. By joining the Health Information and Management Systems Society, legislators gain a structured channel to understand the health issues...

Images: Johns Creek's Sweet Downtown Trail System, Boardwalk Arrives
Johns Creek unveiled a nearly one‑mile elevated multi‑use trail that weaves through woods, follows a creek and connects to the new Boardwalk at Town Center, a centerpiece of the city’s 20‑acre downtown plan. The trail links the Medlock Bridge Pedestrian...
How One HIMSS Member's Policy Work Is Shaped by Experience
Gayle Harrell, a Florida state senator and 2026 HIMSS Changemaker, used her experience running a medical practice to shape health‑IT legislation. Her frontline insight led to new Florida bills that update HITECH compliance and mandate electronic prescribing. The policies aim...

FFXIV Announces Neon Genesis Evangelion Crossover, Featuring The Legendary Anime In 24-Player Battles
Square Enix unveiled a major crossover for Final Fantasy XIV’s upcoming Evercold expansion, teaming up with the anime Neon Genesis Evangelion. The collaboration will debut a 24‑player Alliance Raid titled “Ghosts of Desire,” marking the series’ 30th anniversary and supervised by Evangelion studio...

Square Enix Confirms FFXIV Switch 2 Release Date and Extra Subscription
Square Enix announced that Final Fantasy XIV will debut on Nintendo Switch 2 in August 2026, bringing the long‑running MMO to Nintendo’s next‑gen console. The launch comes with a new subscription requirement: Switch 2 players must purchase a separate FF XIV subscription, though existing...

FDA Grants Three Priority Vouchers to Psychedelics
The FDA has granted three Commissioner's National Priority Vouchers to psychedelic‑focused firms—Compass Pathways, Transcend Therapeutics and the Usona Institute—following President Trump’s executive order to accelerate mental‑health treatments. All three companies already hold Breakthrough Therapy Designations, and the vouchers promise faster...

Trump Admin Eyes New Fertilizer Plants, a Fix to Address High Fertilizer Costs
The Trump administration announced a push to expand U.S. nitrogen fertilizer production, aiming to cut permitting timelines and build new plants within three years. Agriculture Secretary Brooke Rollins said the effort will target the country’s reliance on Russian and Chinese...

Crimson Desert 1.04 Update: Pet Birds, Housing Changes, and More Cats
Pearl Abyss released Crimson Desert patch 1.04, adding tamable pet birds and a new Sigil of Bonding that lets cats remain on a player’s shoulder longer. The update overhauls the housing system with four new storage containers and the ability...
Hospital Gift Shop Chain Pays $600K over Allegedly Unnecessary Standing, Lifting Requirements
Hospital gift‑shop chain Lori’s Gifts agreed to pay $600,000 to settle EEOC claims that it unlawfully rejected candidates with disabilities. The EEOC alleged the retailer’s pre‑employment questionnaire required applicants to stand for up to five hours and lift 30 pounds, criteria...
‘Zealous Implementation’ of Trump Anti-Trans Order Resulted in Hostile Work Environment at EEOC, Lawsuit Says
A transgender former EEOC director of information governance filed a lawsuit alleging a hostile work environment created by the agency’s aggressive implementation of President Trump’s anti‑transgender executive order. The complaint says Chair Andrea Lucas rescinded long‑standing LGBTQ+ protections, disbanded the employee...

Deephaven Residential Mortgage Trust 2026-CES1: Presale Report
Morningstar DBRS has issued provisional credit ratings for the Deephaven Residential Mortgage Trust 2026‑CES1 series, covering eight distinct classes of mortgage‑backed notes. The three most senior classes (A‑1, A‑1A, A‑1B) received a (P) AAA rating, while the next tier (A‑2) was...

'Ransom Canyon' Star: Season 2 Is Coming 'Sooner Than You Know'
Netflix drama *Ransom Canyon* is poised for a second season, with star Garrett Wareing teasing that it could arrive sooner than the 2027 timeline rumored after the series was omitted from Netflix's 2026 lineup preview. Production wrapped in January 2026...

Whole Foods Market Preps New Store In Downtown Jacksonville, FL
Whole Foods Market is set to launch a 38,432‑square‑foot store on May 21 at 1 Riverside Ave in downtown Jacksonville, Florida. The new location will carry more than 800 products sourced from over 115 Florida‑based suppliers, emphasizing local produce, seafood,...

Preview ESO's Night Market Factions, Rewards, and How Your Choice Impacts Your Experience
The Elder Scrolls Online’s Night Market opens on April 29, introducing an event zone with an introductory quest. Players encounter three rival factions—Glittering Goad, The Ruckus, and The Thousand Eyes—and must pledge allegiance for the event’s duration. Favor earned by completing...

ALONE-AF: Stopping OAC After Ablation Doesn’t Reduce Cognitive Function
A substudy of the ALONE‑AF trial found that stopping oral anticoagulation (OAC) after successful catheter ablation did not lead to cognitive decline over two years. Montreal Cognitive Assessment (MoCA) scores rose modestly in both the OAC and no‑OAC groups, with...

IHeartMedia in Talks to Merge With SiriusXM
Irving Azoff, the veteran music manager, is reportedly in talks to acquire both iHeartMedia and SiriusXM, aiming to merge the nation’s largest terrestrial radio network with the leading satellite and streaming platform. The combined entity would control over 860 radio...

How Jet Fuel Shortages Could Affect Summer Travel to Europe and Beyond
Jet fuel prices have jumped more than 70% since the Iran‑Russia conflict escalated in February, tightening supplies across Europe and prompting airlines such as Lufthansa and KLM to slash schedules. The surge is driving U.S. carriers to face billions in...

Air India Selects Hughes IFC for Airbus and Boeing Fleet
Air India Limited has signed an inflight connectivity (IFC) agreement with Hughes to equip its Airbus and Boeing wide‑body fleet with satellite‑based broadband. The partnership will deliver consistent, global Wi‑Fi coverage for passengers and crew, regardless of route. Hughes will...

Federal Reserve Board Announces Approval of Application by Banco De Credito Del Peru
The Federal Reserve Board approved Banco de Credito del Peru’s application to open a state‑licensed branch in Coral Gables, Florida, announced on April 24, 2026. The Peruvian bank will now be authorized to offer U.S. dollar deposits and loan services...
Tractor Supply Get Help From Digital Sales in Q1 Earnings Results
Tractor Supply reported fiscal Q1 net sales of $3.59 billion, a 3.6% year‑over‑year increase, helped by the opening of 40 new stores. Comparable store sales rose only 0.5%, reflecting softer discretionary spending on pet supplies. Digital channels delivered a bright spot,...

US Sanctions Giant Chinese Refiner Hengli Over Iran Links
U.S. Treasury’s Office of Foreign Assets Control placed Hengli Petrochemical (Dalian) Refinery Co., one of China’s largest private refiners, on its sanctions list for buying Iranian oil. The action intensifies Washington’s campaign to choke Iran’s oil revenues while signaling a...

AHA Urges Delay on TEFCA Individual Access SOP over Patient Privacy Concerns
The American Hospital Association (AHA) has urged the Sequoia Project to postpone the rollout of version 3.0 of the Trusted Exchange Framework and Common Agreement (TEFCA) Individual Access Services (IAS) Standard Operating Procedures, originally slated for August 2027. The AHA argues that...

U.S. Targets Major Chinese Refinery and Ships in Escalating Crackdown on Iran’s Oil Trade
The U.S. Treasury’s Office of Foreign Assets Control sanctioned China’s Hengli Petrochemical (Dalian) Refinery, the nation’s second‑largest independent refinery and a major buyer of Iranian crude, and blacklisted 19 tankers and 18 shipping entities tied to Iran’s shadow fleet. This...
A Common Stomach Bug Has Become Harder to Treat
A growing share of shigella infections are drug-resistant, the C.D.C. warns in a new report.

Final Fantasy 14 Evercold Promises to Respect Your "Limited Free Time" As Yoshi-P Teases the Death of Tomestones and Daily...
Square Enix unveiled Final Fantasy 14’s 8.0 Evercold update, replacing daily roulettes with a weekly mission rotation that awards activity points toward gear. The long‑standing Allagan tomestone system will be retired after 13 years, ending the grind for incremental upgrades. A new...

Battlefield Movie Coming From Michael B. Jordan
Michael B. Jordan is teaming with director Christopher McQuarrie to develop a film adaptation of Electronic Arts' Battlefield franchise. McQuarrie will write, direct and produce while Jordan will produce and may star, with EA also listed as a producer. The project is being...

Finovate Global Libya: Chatbots, Payments, and Expanding E-Wallet Access
Libya’s Tadhamun Bank has teamed with India‑based JMR Infotech to launch an AI‑powered chatbot and voicebot that will handle onboarding, transfers and queries across web, WhatsApp and Messenger. UAE‑based Network International signed a deal with Al Seraj Islamic Bank to provide...
NTSB Cites Engine Corrosion In Fatal Hop-A-Jet Accident
The NTSB’s final report attributes the February 9, 2024 Hop‑A‑Jet Challenger 604 crash to corrosion in the variable geometry (VG) systems of both GE CF34‑3B engines, which caused near‑simultaneous compressor stalls and loss of thrust on approach. The aircraft, operating...
FCC Threatens to Revoke Montana FM’s License
The FCC’s Media Bureau has opened a revocation proceeding against 100.9 KBOQ (FM) in southwest Montana after its owner, Southwest Montana Media, failed to pay approximately $6,750 in delinquent regulatory fees, administrative costs, and penalties. The unpaid balances span fees from 2019...

The Biglaw EO Cases Head To The D.C. Circuit With A Hall-Of-Fame Advocate — And One Very Thirsty Judge
Four major law firms—Perkins Coie, Jenner & Block, WilmerHale, and Susman Godfrey—are taking their challenge to Trump’s retaliatory executive orders to the D.C. Circuit, with former Solicitor General Paul Clement leading the defense. The firms argue the orders violate the...

The BioPharm Brief: Innovation, Gene Therapy Momentum, and Next-Gen ADCs Lead Today’s Headlines
The latest Ron Lanton Report shows biopharma innovation moving beyond Boston and San Francisco into emerging regions powered by academic collaborations, venture capital, and niche talent pools. The European Medicines Agency issued a positive opinion on Novartis’ intrathecal onasemnogene abeparvovec, expanding...

Chapters Health Unveils New Pediatric Hospice Program
Chapters Health System, one of the nation’s largest nonprofit hospice networks, has launched Chapters Kids, a pediatric hospice and palliative‑care program serving more than 300 seriously ill children across eight states. The model provides concurrent hospice, letting patients continue curative...
HFMA’s P&P Board Comments on GASB’s Proposed Implementation Guide, Financial Reporting Model Improvements-Subsidies
On April 24, 2026, the Healthcare Financial Management Association’s Principles and Practices Board submitted formal comments on the Governmental Accounting Standards Board’s Proposed Implementation Guide for Financial Reporting Model Improvements‑Subsidies. The board’s letter tackles five key areas: the proposed effective...

For Port of Montreal, ‘Solid’ 2025 Results
The Montreal Port Authority posted solid 2025 results, with operating revenue climbing to C$155.4 million (≈ $113 million USD) and net income reaching C$24.2 million (≈ $17.7 million USD). Container volumes rose 3.6% to 1.52 million TEUs, while overall tonnage slipped modestly amid geopolitical headwinds and low...

Houthis Remain on the Sideline While Iran Threatens to Widen Conflict
Iranian hardliners, led by IRGC‑linked officials, have escalated rhetoric, threatening undersea cable attacks and a list of Saudi oil‑related targets if the Red Sea cease‑fire collapses. Major General Ali Abdollahi Aliabadi warned that continued interception of Iranian merchant ships would...

The Corvette E-Ray Is One of the Last Cars That Should Have Auto-Stop/Start, And Yet
Chevrolet’s 2024 Corvette E‑Ray, one of only two C8 models equipped with auto‑start/stop, brings the fuel‑saving feature to a high‑performance V8 platform. The system re‑engages at every stop and cannot be permanently disabled, forcing drivers to toggle it manually each...

Advisory Details Shifting Tactics of Chinese Cyber Actors Using Covert Networks for Malicious Activity
A joint advisory from U.S. and international cyber agencies warns that China‑aligned threat actors have shifted to large‑scale covert networks of compromised routers, IoT devices, and other edge hardware. These hidden botnets let attackers mask origins, evade defenses, and target...

VW Is Making a Golf with a 'Full' Hybrid, but Will It Come to the US?
Volkswagen unveiled a full‑hybrid version of its Golf hatchback, slated for a Europe‑only release in the fourth quarter of 2026, alongside a similarly equipped T‑Roc SUV. The powertrain pairs a turbocharged gasoline engine with a generator that drives two electric...
K+N Develops New Ocean Markets, Air Freight Measures to Offset War Impact
Kuehne + Nagel reported a 12% year‑over‑year drop in first‑quarter net profit, down to $316 million, as the Middle East war strained air‑freight operations. To counteract the disruption, the logistics giant is expanding prepaid ocean‑freight services in China and establishing aircraft‑refueling...

This Is a ‘Come to Jesus Moment’: Ford CEO Says American Carmakers Are Battling a Perfect Storm
Ford CEO Jim Farley warned that automakers face three "perfect‑storm" challenges: Chinese rivals now outselling Western brands in China, the rising complexity of software‑defined electric vehicles, and a regulatory whiplash that could undo emissions gains. He cited Chinese sales overtaking...

Best New Xbox Game Pass Games to Play This Weekend (April 24-26)
Microsoft recently cut the Xbox Game Pass price while confirming that upcoming Call of Duty releases won’t launch on the service day‑and‑date. Despite the pricing shift, the platform added three notable titles in April—Vampire Crawlers, Kiln, and Replaced—bringing the catalog...

FCC: Router Ban Includes Portable Hotspots, but Not Phones with Hotspot Features
The FCC clarified that its ban on foreign‑made consumer routers now also covers portable MiFi hotspot devices, while mobile phones with hotspot capabilities remain exempt. The agency’s FAQ defines the ban to include consumer‑grade routers, LTE/5G CPEs, and residential gateways,...
![BYD Is About to Unleash This 1,000+ Hp Drop-Top Electric Hypercar in Europe [Images]](/cdn-cgi/image/width=1200,quality=75,format=auto,fit=cover/https://i0.wp.com/electrek.co/wp-content/uploads/sites/3/2026/04/BYD-Denza-Z-electric-hypercar-side.jpeg?resize=1200%2C628&quality=82&strip=all&ssl=1)
BYD Is About to Unleash This 1,000+ Hp Drop-Top Electric Hypercar in Europe [Images]
Chinese automaker BYD unveiled the Denza Z, a four‑seat, drop‑top electric hypercar boasting over 1,000 horsepower and 0‑62 mph acceleration in under two seconds. The model features a carbon‑fiber body, the company’s Blade Battery paired with Flash Charging 2.0 that can refill...